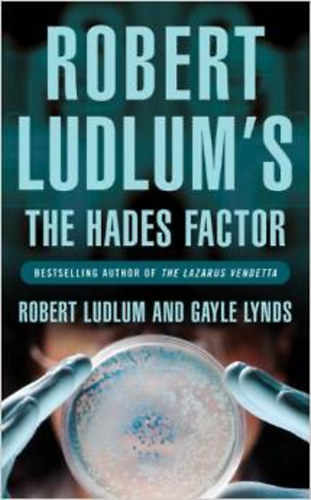
Robert Ludlum's & Gayle Lynds - Robert Ludlum's the Hades Factor

Antikvár könyvek - Egyéb
0 | nemzeti tankönyvkiadó | 2005
A Gyakorlólapok a síkidomok szerkesztéséhez című kiadványunk a szerkesztés...
Szállítási idő:
4-6 munkanap
129 pontot ér
0 | budapest | 2005
Szállítási idő:
4-6 munkanap
189 pontot ér
0 | közlekedési múzeum | 2005
Szállítási idő:
4-6 munkanap
94 pontot ér
0 | debolsillo | 2005
Vivir para contarla es, probablemente, el libro más esperado de la primera década del siglo...
Szállítási idő:
4-6 munkanap
499 pontot ér
0 | nógrádi tört. múzeum | 2005
Szállítási idő:
4-6 munkanap
349 pontot ér
0 | magyar könyvklub | 2005
Nincs más kiút, mint a 180 fokos fordulat!... A vérszívó, parazita elemek tobzódását meg...
Szállítási idő:
4-6 munkanap
94 pontot ér
0 | vagabund kiadó | 2005
Az amerikai hírszerző szolgálat sötét ügyeiről számos mendemonda kering, különösen...
Szállítási idő:
6-8 munkanap
94 pontot ér
3 db szegedi helytörténeti kötet: A Szegedi Tudományegyetem évkönyve 2003-2005, 2005-2006, 2007-2008
3 db szegedi helytörténeti kötet: A Szegedi Tudományegyetem évkönyve 2003-2005, 2005-2006, 2007-2008
0 | szeged | 2005
Szállítási idő:
6-8 munkanap
480 pontot ér
0 | palgrave | 2005
During the course of the twentieth century, nineteen men and one woman--from the Third Marquis of...
Szállítási idő:
6-8 munkanap
200 pontot ér
0 | grimm könyvkiadó | 2005
Szállítási idő:
4-6 munkanap
99 pontot ér
0 | penguin books ltd | 2005
"DK Eyewitness Top 10 Travel Guide: Hong Kong" will lead you straight to the very best of...
Szállítási idő:
4-6 munkanap
699 pontot ér
0 | európa könyvkiadó | 2005
Kolnai Aurél neve talán már nem cseng teljesen ismeretlenül a magyar szellemi életben...
Szállítási idő:
4-6 munkanap
219 pontot ér
0 | criticai lapok | 2005
FÜLSZÖVEG 1949. JÚNIUS 30. Tegnap a Művész Színház végleg bezárta kapuit, a Cander...
Szállítási idő:
4-6 munkanap
119 pontot ér
0 | akadémiai kiadó | 2005
Regionalpolitik im Alten Europa ist die erste Monographie, die die Verwaltungsreformen Josephs II...
Szállítási idő:
4-6 munkanap
400 pontot ér
0 | forrás kiadó | 2005
Szállítási idő:
6-8 munkanap
148 pontot ér
0 | ernst múzeum | 2005
Szerzők: Allan Siegel, Helen Tangires, Samuele Martelli, Malgorzata Omilanowska, Linda Gran, Vadas...
Szállítási idő:
4-6 munkanap
94 pontot ér
0 | puffin books | 2005
Illustrated by Pamela Lofts
Szállítási idő:
6-8 munkanap
328 pontot ér
0 | orion publishing group | 2005
An unknown doomsday virus has claimed the lives of four people - including the fiancee of Covert...
Szállítási idő:
4-6 munkanap
189 pontot ér
0 | chatto & windus | 2005
Fresh, innovative, versatile and delicious, it's sultry summer all year round and from around the...
Szállítási idő:
4-6 munkanap
239 pontot ér
0 | harper perennial | 2005
Fifteen-year-old Kambili and her older brother Jaja lead a privileged life in Enugu, Nigeria. They...
Szállítási idő:
6-8 munkanap
399 pontot ér